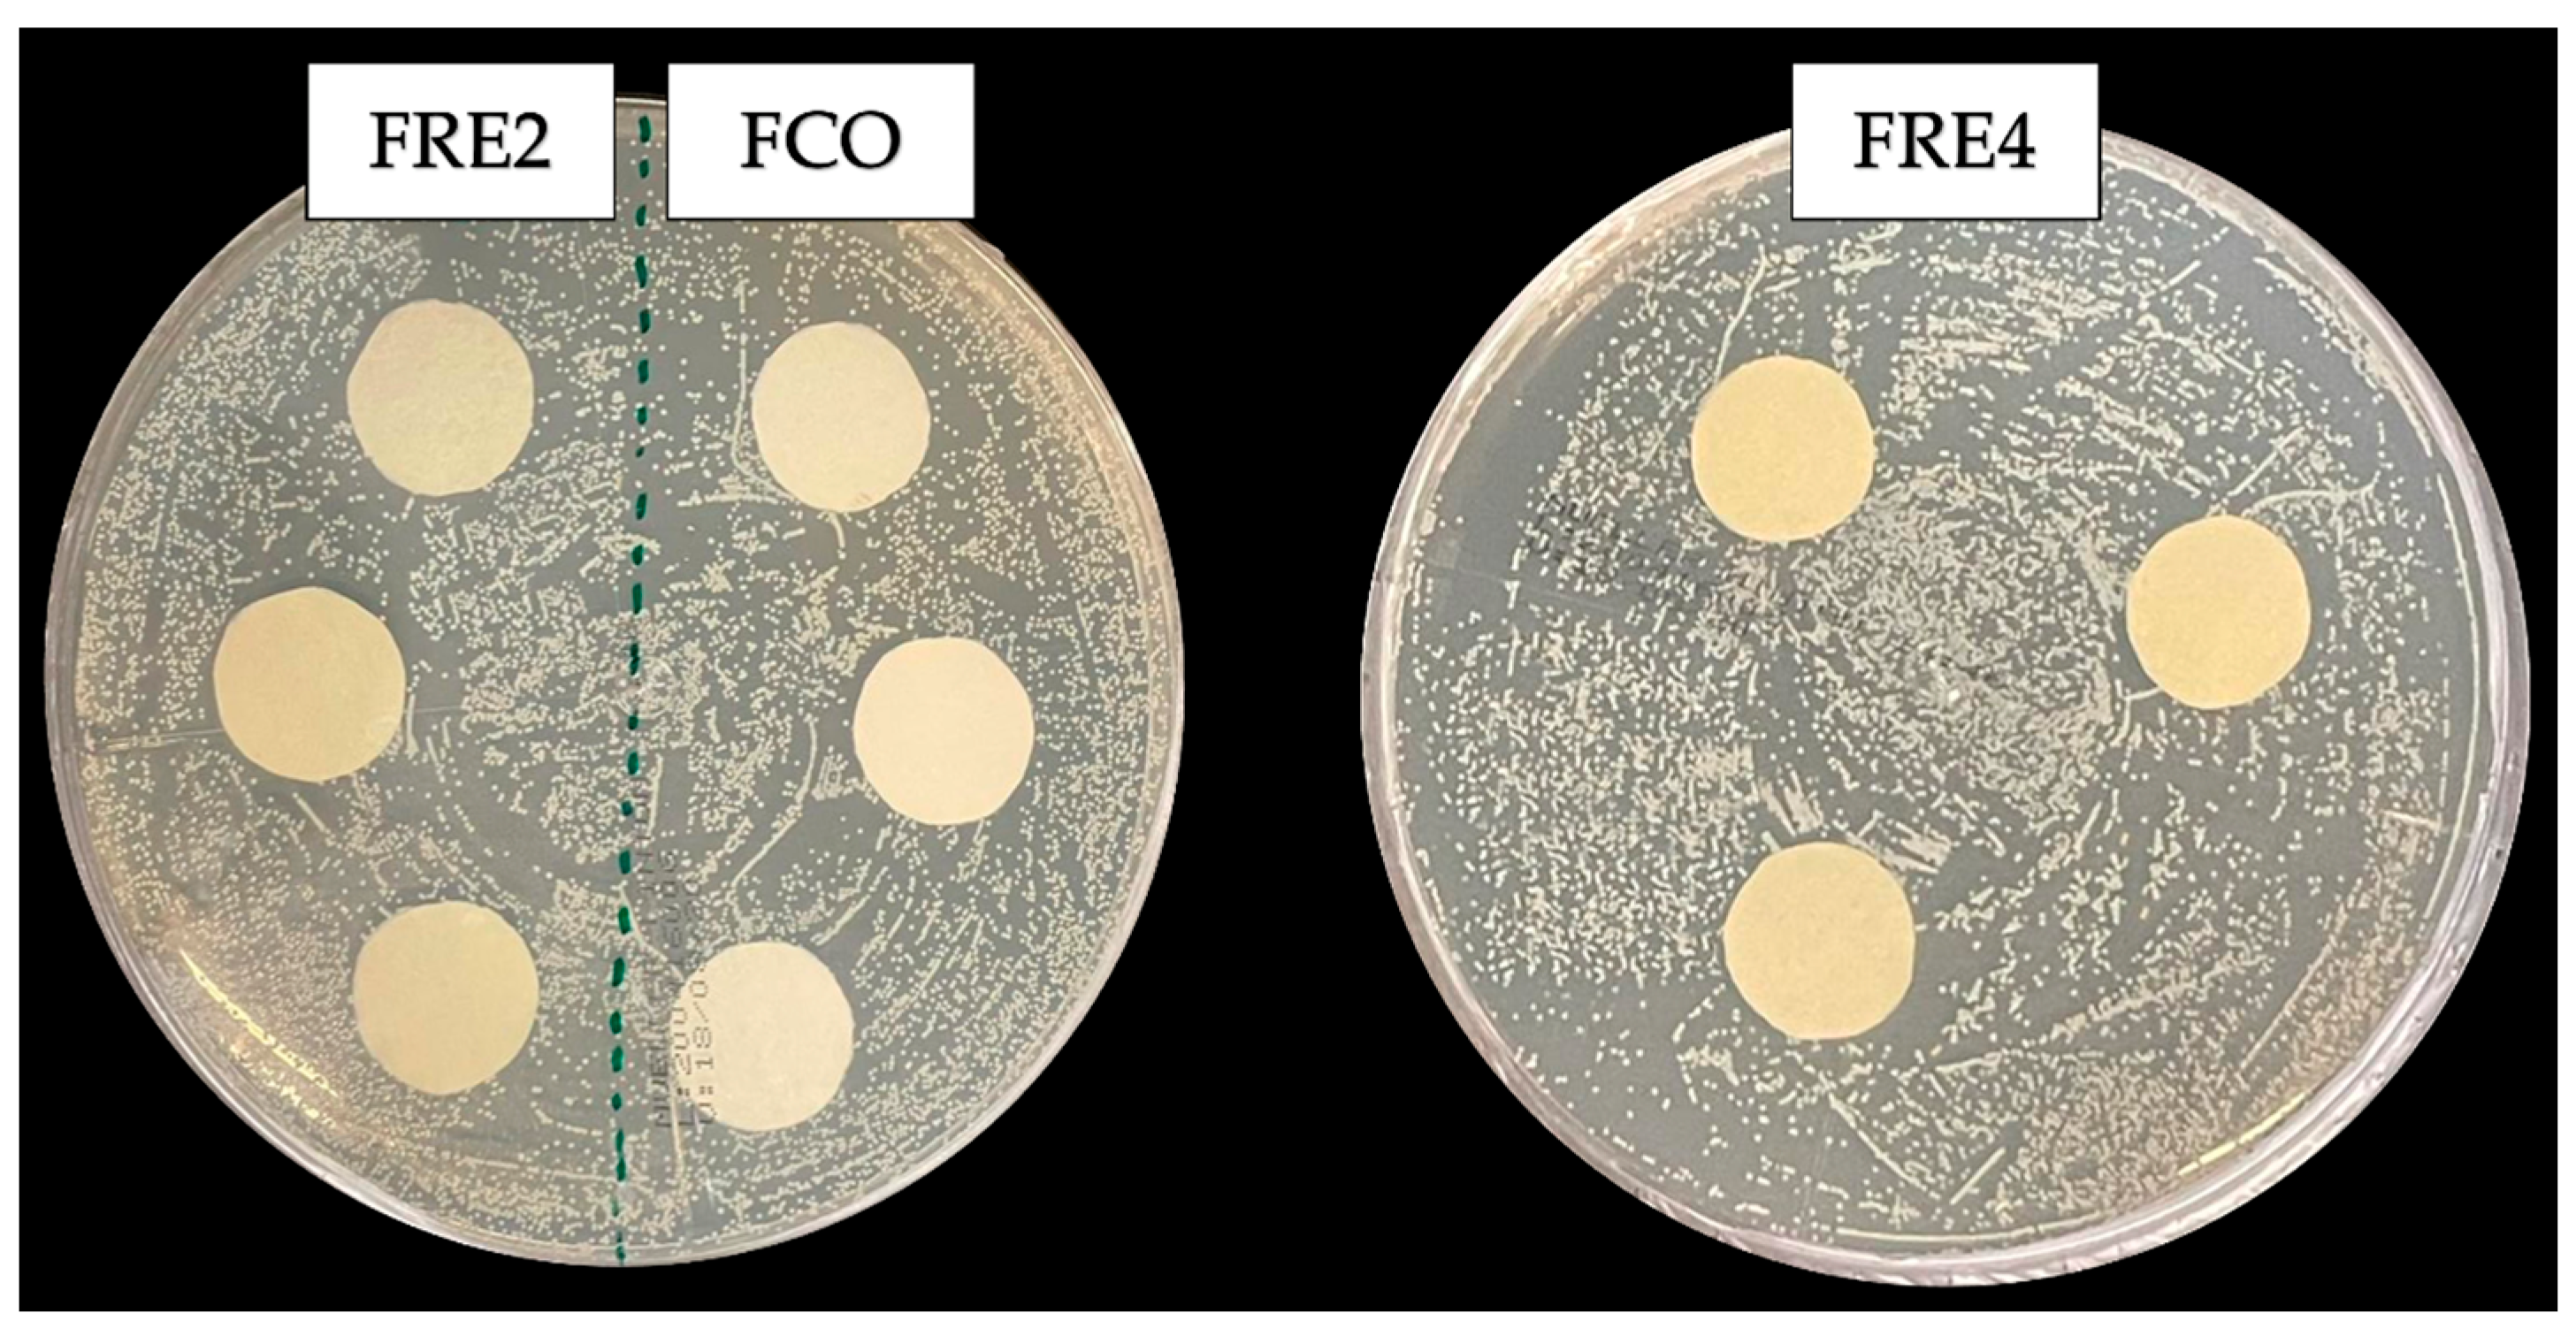

Development and Characterization of Wheat Flour Byproduct and Poly(butylene adipate-co-terephthalate) Biodegradable Films Enriched with Rosemary Extract via Blown Extrusion
Abstract
1. Introduction
2. Materials and Methods
2.1. Materials
2.2. Production of GF/PBAT Films via Blown Extrusion
2.3. Film Characterization
2.3.1. Color and Apparent Opacity
2.3.2. Thickness, Density, and Grammage
2.3.3. Moisture and Solubility in Water
2.3.4. Sorption Isotherm
2.3.5. Water Vapor Permeability (WVP)
2.3.6. Coefficients of Solubility and Water Diffusion
2.3.7. Tensile Strength, Young’s Modulus, and Elongation at Break
2.3.8. Morphology
2.3.9. Fourier-Transform Infrared (FT-IR)
2.3.10. X-Ray Diffraction
2.3.11. Thermal Properties
2.3.12. Antimicrobial Activity
2.3.13. Biodegradation Tests
2.4. Statistical Analysis
3. Results and Discussion
3.1. Visual Aspects and Color Measurements
3.2. Thickness, Grammage, and Density
3.3. Moisture and Solubility
3.4. Sorption Isotherms in Biodegradable Films
3.5. Water Vapor Permeability (WVP), Solubility (β), and Diffusion Coefficient (Dw)
3.6. Mechanical Properties
3.7. Surface Morphology and Microstructure
3.8. ATR-FTIR
3.9. Crystallinity
3.10. Characterization of Thermal Properties
3.11. Assessment of Antimicrobial Activity
3.12. Biodegradability in Simulated Soil
3.13. Study Limitations
4. Conclusions
Author Contributions
Funding
Institutional Review Board Statement
Informed Consent Statement
Data Availability Statement
Acknowledgments
Conflicts of Interest
References
- Ariffin, F.; Kamilah, H.; Mahmood, K.; Karima, A.A. Biomaterials for Food Packaging: An Overview. In Biomaterials in Food Packaging; Yusuf, M., Khan, S.A., Eds.; Jenny Stanford Publishing Pte. Ltd.: Singapore, 2022; pp. 1–48. [Google Scholar]
- Abdillahi, H.; Chabrat, E.; Rouilly, A.; Rigal, L. Influence of Citric Acid on Thermoplastic Wheat Flour/Poly(Lactic Acid) Blends. II. Barrier Properties and Water Vapor Sorption Isotherms. Ind. Crops Prod. 2013, 50, 104–111. [Google Scholar] [CrossRef]
- Peron-Schlosser, B.; Carpiné, D.; Matos Jorge, R.M.; Rigon Spier, M. Optimization of Wheat Flour by Product Films: A Technological and Sustainable Approach for Bio-Based Packaging Material. J. Food Sci. 2021, 86, 4522–4538. [Google Scholar] [CrossRef] [PubMed]
- Peron-Schlosser, B.; Beux, M.R.; Heemann, A.C.W.; Jorge, R.M.M.; Spier, M.R. Development and Characterization of Wheat Mill By-Product Films Enriched with Commercial Rosemary Extract. Acta Scientiarum Technol. 2024, 46, e66401. [Google Scholar] [CrossRef]
- Peron-Schlosser, B.; Ramos, R.M.B.; Paludo, L.C.; Monteiro, P.I.; de Carvalho, F.A.; da Silva, S.C.; Cordova, B.A.B.; Carvalho, B.d.M.; Yamashita, F.; Spier, M.R. Injection-Molded Poly(Butylene Succinate)/Wheat Flour By-Product Biocomposites: Mechanical, Thermal, and Structural Characterization. Processes 2025, 13, 1044. [Google Scholar] [CrossRef]
- Benincasa, P.; Dominici, F.; Bocci, L.; Governatori, C.; Panfili, I.; Tosti, G.; Torre, L.; Puglia, D. Relationships between Wheat Flour Baking Properties and Tensile Characteristics of Derived Thermoplastic Films. Ind. Crops Prod. 2017, 100, 138–145. [Google Scholar] [CrossRef]
- Pelissari, F.M.; Andrade-Mahecha, M.M.; Sobral, P.J.d.A.; Menegalli, F.C. Optimization of Process Conditions for the Production of Films Based on the Flour from Plantain Bananas (Musa paradisiaca). LWT-Food Sci. Technol. 2013, 52, 1–11. [Google Scholar] [CrossRef]
- Balan, G.C.; Paulo, A.F.S.; Correa, L.G.; Alvim, I.D.; Ueno, C.T.; Coelho, A.R.; Ströher, G.R.; Yamashita, F.; Sakanaka, L.S.; Shirai, M.A. Production of Wheat Flour/PBAT Active Films Incorporated with Oregano Oil Microparticles and Its Application in Fresh Pastry Conservation. Food Bioprocess Technol. 2021, 14, 1587–1599. [Google Scholar] [CrossRef]
- Silva, I.C.S.; da Silva, P.J.; de Carvalho, F.A.; da Silva, S.C.; Yamashita, F.; Mendes, A.L.D.; Goto, C.A.; Bosco, T.C.D.; Balan, G.C.; Shirai, M.A. Malt Bagasse in Extruded Wheat Flour and PBAT Biodegradable Films. Ind. Crops Prod. 2024, 220, 119274. [Google Scholar] [CrossRef]
- Tanada-Palmu, P.S.; Grosso, C.R.F. Development and Characterization of Edible Films Based on Gluten from Semi-Hard and Soft Brazilian Wheat Flours (Development of Films Based on Gluten from Wheat Flours). Ciência Technol. Aliment. 2003, 23, 264–269. [Google Scholar] [CrossRef]
- Leblanc, N.; Saiah, R.; Beucher, E.; Gattin, R.; Castandet, M.; Saiter, J.-M. Structural Investigation and Thermal Stability of New Extruded Wheat Flour Based Polymeric Materials. Carbohydr. Polym. 2008, 73, 548–557. [Google Scholar] [CrossRef]
- Gao, S.; Zhai, X.; Cheng, Y.; Zhang, R.; Wang, W.; Hou, H. Starch/PBAT Blown Antimicrobial Films Based on the Synergistic Effects of Two Commercial Antimicrobial Peptides. Int. J. Biol. Macromol. 2022, 204, 457–465. [Google Scholar] [CrossRef]
- Rodrigues, S.C.S.; De Mesquita, F.A.S.; De Carvalho, L.H.; Alves, T.S.; Folkersma, R.; Araújo, R.S.D.R.M.; Oliveira, A.D.; Barbosa, R. Preparation and Characterization of Polymeric Films Based on PLA, PBAT and Corn Starch and Babassu Mesocarp Starch by Flat Extrusion. Mater. Res. Express 2021, 8, 035305. [Google Scholar] [CrossRef]
- Ferreira, F.V.; Cividanes, L.S.; Gouveia, R.F.; Lona, L.M.F. An overview on properties and applications of poly(butylene adipate-co-terephthalate)–PBAT based composites(Review). Polym. Eng. Sci. 2019, 59, E7–E15. [Google Scholar] [CrossRef]
- Maria, T.M.C.; de Carvalho, R.A.; Sobral, P.J.A.; Habitante, A.M.B.Q.; Solorza-Feria, J. The Effect of the Degree of Hydrolysis of the PVA and the Plasticizer Concentration on the Color, Opacity, and Thermal and Mechanical Properties of Films Based on PVA and Gelatin Blends. J. Food Eng. 2008, 87, 191–199. [Google Scholar] [CrossRef]
- ASTM E96/E96M-16; Standard Test Methods for Water Vapor Transmission of Materials. American Society for Testing and Materials: Philadelphia, PA, USA, 2016; pp. 1–14.
- Larotonda, F.D.S.; Matsui, K.N.; Sobral, P.J.A.; Laurindo, J.B. Hygroscopicity and Water Vapor Permeability of Kraft Paper Impregnated with Starch Acetate. J. Food Eng. 2005, 71, 394–402. [Google Scholar] [CrossRef]
- ASTM D882-18; Standard Test Method for Tensile Properties of Thin Plastic Sheeting. American Society for Testing and Materials: Philadelphia, PA, USA, 2018; pp. 1–12.
- Köksel, H.; Şahbaz, F.; Özboy, Ö. Influence of Wheat-Drying Temperatures on the Birefringence and X-Ray Diffraction Patterns of Wet-Harvested Wheat Starch. Cereal Chem. 1993, 70, 481–483. [Google Scholar]
- CLSI—Clinical and Laboratory Standards Institute. Performance Standards for Antimicrobial Disk Susceptibility Tests, 8th ed.; Clinical and Laboratory Standards Institute: Wayne, PA, USA, 2003. [Google Scholar]
- G160-12; Standard Practice for Evaluating Microbial Susceptibility of Nonmetallic Materials by Laboratory Soil Burial. American Society for Testing and Materials: Philadelphia, PA, USA, 2019; pp. 1–3.
- de Campos, S.S.; de Oliveira, A.; Moreira, T.F.M.; da Silva, T.B.V.; da Silva, M.V.; Pinto, J.A.; Bilck, A.P.; Gonçalves, O.H.; Fernandes, I.P.; Barreiro, M.F.; et al. TPCS/PBAT Blown Extruded Films Added with Curcumin as a Technological Approach for Active Packaging Materials. Food Packag. Shelf Life 2019, 22, 100424. [Google Scholar] [CrossRef]
- da Silva, J.B.A.; Santana, J.S.; de Almeida Lucas, A.; Passador, F.R.; de Sousa Costa, L.A.; Pereira, F.V.; Druzian, J.I. PBAT/TPS-Nanowhiskers Blends Preparation and Application as Food Packaging. J. Appl. Polym. Sci. 2019, 136, 47699. [Google Scholar] [CrossRef]
- Mücke, N.; da Silva, T.B.V.; de Oliveira, A.; Moreira, T.F.M.; Venancio, C.D.S.; Marques, L.L.M.; Valderrama, P.; Gonçalves, O.H.; da Silva-Buzanello, R.A.; Yamashita, F.; et al. Use of Water-Soluble Curcumin in TPS/PBAT Packaging Material: Interference on Reactive Extrusion and Oxidative Stability of Chia Oil. Food Bioprocess Technol. 2021, 14, 471–482. [Google Scholar] [CrossRef]
- Galdeano, M.C.; Wilhelm, A.E.; Mali, S.; Victória, M.; Grossmann, E. Influence of Thickness on Properties of Plasticized Oat Starch Films. Braz. Arch. Biol. Technol. 2013, 56, 637–644. [Google Scholar] [CrossRef]
- Kraus, L.; Hopmann, C.; Facklam, M.; Grüber, D. Investigations of Film Thickness Variations in Blown Film Extrusion When Using Air Guiding Systems. J. Plast. Film Sheeting 2020, 37, 33–52. [Google Scholar] [CrossRef]
- Bastarrachea, L.; Dhawan, S.; Sablani, S.S. Engineering Properties of Polymeric-Based Antimicrobial Films for Food Packaging. Food Eng. Rev. 2011, 3, 79–93. [Google Scholar] [CrossRef]
- Santos, R.A.L.; Muller, C.M.O.; Grossmann, M.V.E.; Mali, S.; Yamashita, F. Starch/Poly (Butylene Adipate–Co-Terephthalate)/Montmorillonite Films Produced by Blow Extrusion. Quim. Nova 2014, 37, 937–942. [Google Scholar] [CrossRef]
- Fialho e Moraes, A.R.; Pola, C.C.; Bilck, A.P.; Yamashita, F.; Tronto, J.; Medeiros, E.A.A.; Soares, N.d.F.F. Starch, Cellulose Acetate and Polyester Biodegradable Sheets: Effect of Composition and Processing Conditions. Mater. Sci. Eng. C 2017, 78, 932–941. [Google Scholar] [CrossRef] [PubMed]
- Almeida, D.M.; Woiciechowski, A.L.; Wosiacki, G.; Prestes, R.A.; Pinheiro, L.A. Propriedades Físicas, Químicas e de Barreira Em Filme Formados Por Blenda de Celulose Bacteriana e Fécula de Batata. Polimeros 2013, 23, 538–546. [Google Scholar] [CrossRef]
- Gallo-García, L.A.; Peron-Schlosser, B.; Carpiné, D.; de Oliveira, R.M.; Simões, B.M.; Dias, A.P.; Yamashita, F.; Spier, M.R. Feasibility of Production Starch/Poly(Butylene Adipate-Co-Terephthalate) Biodegradable Materials with Microalgal Biomass by Blown Film Extrusion. J. Food Process Eng. 2022, 45, e14181. [Google Scholar] [CrossRef]
- Flores Fidelis, J.C.; Marchi, L.B.; Scapim, M.R.S.; Gobetti, N.D.; Yamashita, F.; Giriboni Monteiro, A.R. Development of Biodegradable Films Containing Pomegranate Peel Extract and Potassium Sorbate. LWT 2022, 160, 113302. [Google Scholar] [CrossRef]
- Elangko, A.Z.N.; Jai, J.; Ali, S.A.; Manshor, N.M. Moisture Sorption Isotherm of Cassava Starch Film Incorporated with Kaffir Lime Oil. ASM Sci. J. 2022, 17. [Google Scholar] [CrossRef]
- Talja, R.A.; Helén, H.; Roos, Y.H.; Jouppila, K. Effect of Type and Content of Binary Polyol Mixtures on Physical and Mechanical Properties of Starch-Based Edible Films. Carbohydr. Polym. 2008, 71, 269–276. [Google Scholar] [CrossRef]
- Reis, H.C.O.; Cossolin, A.S.; Santos, B.A.P.; Castro, K.C. Malt Bagasse Waste as Biosorbent for Malachite Green: An Ecofriendly Approach for Dye Removal from Aqueous Solution. Int. J. Biotechnol. Bioeng. 2018, 12, 118–126. [Google Scholar]
- Basiak, E.; Lenart, A.; Debeaufort, F. How Glycerol and Water Contents Affect the Structural and Functional Properties of Starch-Based Edible Films. Polymers 2018, 10, 412. [Google Scholar] [CrossRef] [PubMed]
- Labuza, T.P.; Altunakar, B. Water Activity Prediction and Moisture Sorption Isotherms. In Water Activity in Foods: Fundamentals and Applications; Barbosa-Cánovas, G.V., Fontana, A.J., Jr., Schmidt, S.J., Labuza, T.P., Eds.; Blackwell Publishing Ltd: Oxford, UK, 2007. [Google Scholar]
- Brandelero, R.P.H.; Yamashita, F.; Grossmann, M.V.E. The Effect of Surfactant Tween 80 on the Hydrophilicity, Water Vapor Permeation, and the Mechanical Properties of Cassava Starch and Poly(Butylene Adipate-Co-Terephthalate) (PBAT) Blend Films. Carbohydr. Polym. 2010, 82, 1102–1109. [Google Scholar] [CrossRef]
- Liu, W.; Liu, S.; Wang, Z.; Liu, J.; Dai, B.; Chen, Y.; Zeng, G. Preparation and Characterization of Compatibilized Composites of Poly(Butylene Adipate-Co-Terephthalate) and Thermoplastic Starch by Two-Stage Extrusion. Eur. Polym. J. 2020, 122, 109369. [Google Scholar] [CrossRef]
- Gao, S.; Zhai, X.; Wang, W.; Zhang, R.; Hou, H.; Lim, L.T. Material Properties and Antimicrobial Activities of Starch/PBAT Composite Films Incorporated with ε-Polylysine Hydrochloride Prepared by Extrusion Blowing. Food Packag. Shelf Life 2022, 32, 100831. [Google Scholar] [CrossRef]
- Garalde, R.A.; Thipmanee, R.; Jariyasakoolroj, P.; Sane, A. The Effects of Blend Ratio and Storage Time on Thermoplastic Starch/Poly(Butylene Adipate-Co-Terephthalate) Films. Heliyon 2019, 5, e01251. [Google Scholar] [CrossRef]
- Puglia, D.; Dominici, F.; Kenny, J.M.; Santulli, C.; Governatori, C.; Tosti, G.; Benincasa, P. Tensile Behavior of Thermoplastic Films from Wheat Flours as Function of Raw Material Baking Properties. J. Polym. Environ. 2016, 24, 37–47. [Google Scholar] [CrossRef]
- Jian, J.; Xiangbin, Z.; Xianbo, H. An Overview on Synthesis, Properties and Applications of Poly(Butylene-Adipate-Co-Terephthalate)–PBAT. Adv. Ind. Eng. Polym. Res. 2020, 3, 19–26. [Google Scholar] [CrossRef]
- Zhai, X.; Wang, W.; Zhang, H.; Dai, Y.; Dong, H.; Hou, H. Effects of High Starch Content on the Physicochemical Properties of Starch/PBAT Nanocomposite Films Prepared by Extrusion Blowing. Carbohydr. Polym. 2020, 239, 116231. [Google Scholar] [CrossRef]
- González-Seligra, P.; Guz, L.; Ochoa-Yepes, O.; Goyanes, S.; Famá, L. Influence of Extrusion Process Conditions on Starch Film Morphology. LWT 2017, 84, 520–528. [Google Scholar] [CrossRef]
- Paulo, A.F.S.; Balan, G.C.; Ströher, G.R.; Yamashita, F.; Bittencourt, P.R.S.; Sakanaka, L.S.; Katsuda, M.S.; Shirai, M.A. Influence of Free and Microencapsulated Oregano Oil on Starch and Poly (Butylene Co-Terephthalate Adipate) Active Film Properties. Polym. Bull. 2022, 79, 4859–4877. [Google Scholar] [CrossRef]
- Brandelero, R.P.H.; Almeida, F.M.D.; Alfaro, A. Microestrutura e Propriedades de Filmes de Amido-Álcool Polivinílico-Alginato Adicionados de Óleos Essenciais de Copaíba e Capim Limão. Quim. Nova 2015, 38, 910–916. [Google Scholar]
- Arruda, L.C.; Magaton, M.; Bretas, R.E.S.; Ueki, M.M. Influence of Chain Extender on Mechanical, Thermal and Morphological Properties of Blown Films of PLA/PBAT Blends. Polym. Test. 2015, 43, 27–37. [Google Scholar] [CrossRef]
- Wang, J.; Xu, X.; Cui, B.; Wang, B.; Abd El-Aty, A.M. Changes in the Properties of the Corn Starch Glycerol Film in a Time-Dependent Manner during Gelatinization. Food Chem. 2024, 458, 140183. [Google Scholar] [CrossRef]
- Singh, P.; Wani, A.A.; Langowski, H.-C. Food Packaging Materials: Testing & Quality Assurance; CRC Press: Boca Raton, FL, USA, 2017. [Google Scholar]
- Mohanty, S.; Nayak, S.K. Starch Based Biodegradable PBAT Nanocomposites: Effect of Starch Modification on Mechanical, Thermal, Morphological and Biodegradability Behavior. J. Polym. Environ. 2016, 19, 736–745. [Google Scholar] [CrossRef]
- Dominici, F.; Luzi, F.; Benincasa, P.; Torre, L.; Puglia, D. Biocomposites Based on Plasticized Wheat Flours: Effect of Bran Content on Thermomechanical Behavior. Polymers 2020, 12, 2248. [Google Scholar] [CrossRef] [PubMed]
- Carmona, V.B.; Corrêa, A.C.; Marconcini, J.M.; Mattoso, L.H.C. Properties of a Biodegradable Ternary Blend of Thermoplastic Starch (TPS), Poly(ε-Caprolactone) (PCL) and Poly(Lactic Acid) (PLA). J. Polym. Environ. 2015, 23, 83–89. [Google Scholar] [CrossRef]
- Wang, J.; Sun, X.; Xu, X.; Sun, Q.; Li, M.; Wang, Y.; Xie, F. Wheat Flour-Based Edible Films: Effect of Gluten on the Rheological Properties, Structure, and Film Characteristics. Int. J. Mol. Sci. 2022, 23, 11668. [Google Scholar] [CrossRef] [PubMed]
- Lendvai, L.; Apostolov, A.; Karger-Kocsis, J. Characterization of Layered Silicate-Reinforced Blends of Thermoplastic Starch (TPS) and Poly(Butylene Adipate-Co-Terephthalate). Carbohydr. Polym. 2017, 173, 566–572. [Google Scholar] [CrossRef]
- Aguirre-Joya, J.A.; De Leon-Zapata, M.A.; Alvarez-Perez, O.B.; Torres-León, C.; Nieto-Oropeza, D.E.; Ventura-Sobrevilla, J.M.; Aguilar, M.A.; Ruelas-Chacón, X.; Rojas, R.; Elena, M.; et al. Basic and Applied Concepts of Edible Packaging for Foods. In Food Packaging and Preservation: Handbook of Food Bioengineering; Grumezescu, A.M., Holban, A.M., Eds.; Elsevier Inc.: London, UK, 2018; pp. 1–62. [Google Scholar]
- Cardoso, T.; Esmerino, L.A.; Bolanho, B.C.; Demiate, I.M.; Danesi, E.D.G. Technological Viability of Biobased Films Formulated with Cassava By-Product and Spirulina Platensis. J. Food Process Eng. 2019, 42, e13136. [Google Scholar] [CrossRef]
- Kanwal, A.; Zhang, M.; Sharaf, F.; Li, C. Enzymatic Degradation of Poly (Butylene Adipate Co-Terephthalate) (PBAT) Copolymer Using Lipase B from Candida Antarctica (CALB) and Effect of PBAT on Plant Growth. Polym. Bull. 2021, 79, 9059–9073. [Google Scholar] [CrossRef]
- Dammak, M.; Fourati, Y.; Tarrés, Q.; Delgado-Aguilar, M.; Mutjé, P.; Boufi, S. Blends of PBAT with Plasticized Starch for Packaging Applications: Mechanical Properties, Rheological Behaviour and Biodegradability. Ind. Crops Prod. 2020, 144, 112061. [Google Scholar] [CrossRef]
- ISO 14855-2:2018; Determination of the Ultimate Aerobic Biodegradability of Plastic Materials Under Controlled Composting Conditions—Method by Analysis of Evolved Carbon Dioxide—Part 2: Gravimetric Measurement of Carbon Dioxide Evolved in a Laboratory-Scale Test. International Organization for Standardization: Geneva, Switzerland, 2018.

| Ingredients | Formulations | ||
|---|---|---|---|
| FCO | FRE2 | FRE4 | |
| PBAT (g·100 g−1) | 60 | 60 | 60 |
| GF (g·100 g−1) | 24 | 24 | 24 |
| Glycerol (g·100 g−1) | 16 | 14 | 12 |
| RE (g·100 g−1) | 0 | 2 | 4 |
| Film | L* | a* | b* | ΔE* | Opacity |
|---|---|---|---|---|---|
| FCO | 91.38 ± 0.15 a | −1.65 ± 0.05 b | 9.40 ± 0.38 c | - | 41.14 ± 3.64 b |
| FRE2 | 87.31 ± 0.40 b | −1.84 ± 0.22 b | 28.51 ± 1.25 b | 19.54 ± 1.00 b | 35.51 ± 0.78 c |
| FRE4 | 80.89 ± 0.70 c | 3.59 ± 0.69 a | 49.20 ± 0.95 a | 41.66 ± 1.19 a | 50.95 ± 2.52 a |
| Film | Thickness (mm) | Density (g·cm−3) | Grammage (g·cm−2) | Moisture (%) | Solubility (%) |
|---|---|---|---|---|---|
| FCO | 0.175 ± 0.012 b | 1.11 ± 0.03 a | 0.019 ± 0.002 b | 20.70 ± 0.42 a | 1.09 ± 0.02 b |
| FRE2 | 0.220 ± 0.024 a | 1.04 ± 0.03 a | 0.022 + 0.003 a | 19.17 ± 0.42 b | 1.40 ± 0.08 a |
| FRE4 | 0.233 ± 0.012 a | 1.06 ± 0.06 a | 0.023 ± 0.004 a | 17.07 ± 0.09 c | 1.42 ± 0.13 a |
| Film | GAB Model Parameters | R2 | ||
|---|---|---|---|---|
| m0 * | k * | C | ||
| FCO | 5.2257 | 0.8266 | 10,000 | 0.990 |
| FRE2 | 5.2709 | 0.8072 | 10,000 | 0.995 |
| FRE4 | 3.0256 | 0.9288 | 10,000 | 0.991 |
| Film | ΔRH (%) | WVP (×10−11 g·m−1·s−1·Pa−1) | β (×10−5 g·g−1·Pa−1) | Dw (×10−11 m2·s−1) |
|---|---|---|---|---|
| FCO | 0–62 | 9.03 ± 1.35 a | 2.46 | 3.34 ± 0.49 b |
| FRE2 | 0–62 | 8.95 ± 1.14 a | 2.39 | 3.62 ± 0.06 b |
| FRE4 | 0–62 | 8.88 ± 0.26 a | 1.75 | 4.72 ± 0.51 a |
| Film | TS (MPa) | ELO (%) | YM (MPa) |
|---|---|---|---|
| FCO | 9.29 ± 0.61 a | 889.61 ± 81.00 a | 25.64 ± 1.96 a |
| FRE2 | 8.16 ± 0.49 b | 889.34 ± 99.64 a | 25.43 ± 2.94 a |
| FRE4 | 9.07 ± 0.40 a | 901.68 ± 93.72 a | 27.16 ± 1.95 a |
Disclaimer/Publisher’s Note: The statements, opinions and data contained in all publications are solely those of the individual author(s) and contributor(s) and not of MDPI and/or the editor(s). MDPI and/or the editor(s) disclaim responsibility for any injury to people or property resulting from any ideas, methods, instructions or products referred to in the content. |
© 2025 by the authors. Licensee MDPI, Basel, Switzerland. This article is an open access article distributed under the terms and conditions of the Creative Commons Attribution (CC BY) license (https://creativecommons.org/licenses/by/4.0/).
Share and Cite
Peron-Schlosser, B.; Carvalho, F.A.d.; Paludo, L.C.; Mesquita de Oliveira, R.; Gallo-García, L.A.; Simões, B.M.; Camilo da Silva, S.; Bewzenko Cordova, B.A.; de Melo Carvalho, B.; Yamashita, F.; et al. Development and Characterization of Wheat Flour Byproduct and Poly(butylene adipate-co-terephthalate) Biodegradable Films Enriched with Rosemary Extract via Blown Extrusion. Coatings 2025, 15, 743. https://doi.org/10.3390/coatings15070743
Peron-Schlosser B, Carvalho FAd, Paludo LC, Mesquita de Oliveira R, Gallo-García LA, Simões BM, Camilo da Silva S, Bewzenko Cordova BA, de Melo Carvalho B, Yamashita F, et al. Development and Characterization of Wheat Flour Byproduct and Poly(butylene adipate-co-terephthalate) Biodegradable Films Enriched with Rosemary Extract via Blown Extrusion. Coatings. 2025; 15(7):743. https://doi.org/10.3390/coatings15070743
Chicago/Turabian StylePeron-Schlosser, Bianca, Fabíola Azanha de Carvalho, Luana Cristina Paludo, Rodolfo Mesquita de Oliveira, Luis Alberto Gallo-García, Bruno Matheus Simões, Samuel Camilo da Silva, Bruno Alexandro Bewzenko Cordova, Benjamim de Melo Carvalho, Fabio Yamashita, and et al. 2025. "Development and Characterization of Wheat Flour Byproduct and Poly(butylene adipate-co-terephthalate) Biodegradable Films Enriched with Rosemary Extract via Blown Extrusion" Coatings 15, no. 7: 743. https://doi.org/10.3390/coatings15070743
APA StylePeron-Schlosser, B., Carvalho, F. A. d., Paludo, L. C., Mesquita de Oliveira, R., Gallo-García, L. A., Simões, B. M., Camilo da Silva, S., Bewzenko Cordova, B. A., de Melo Carvalho, B., Yamashita, F., & Rigon Spier, M. (2025). Development and Characterization of Wheat Flour Byproduct and Poly(butylene adipate-co-terephthalate) Biodegradable Films Enriched with Rosemary Extract via Blown Extrusion. Coatings, 15(7), 743. https://doi.org/10.3390/coatings15070743

